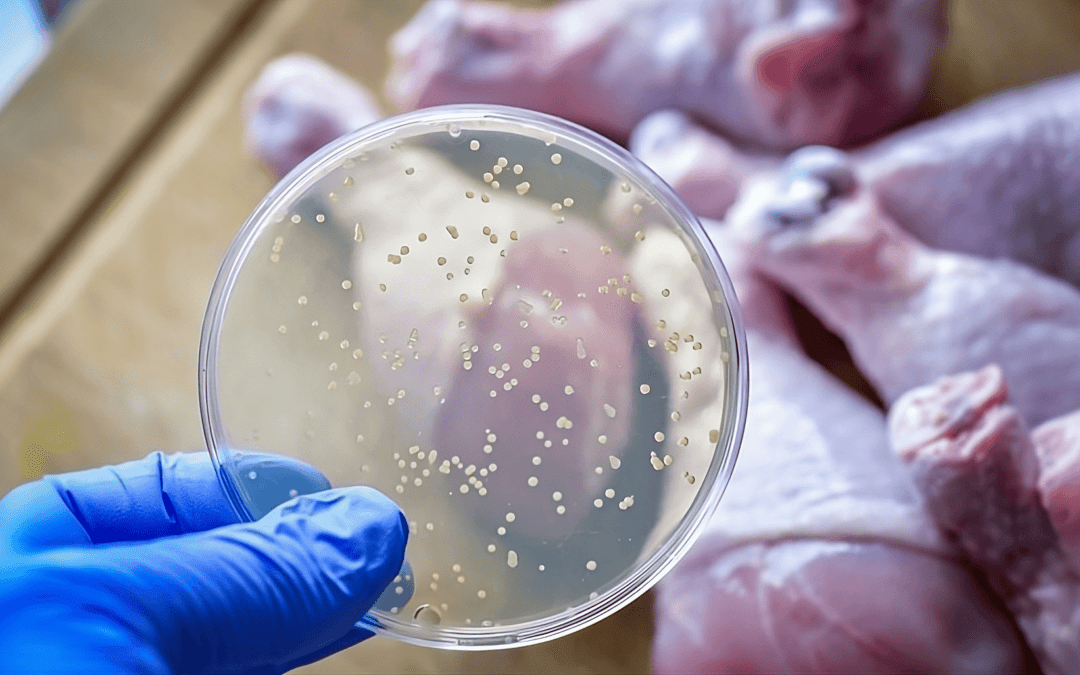
Salmonella Knowledge: SGA’s Industry-Leading Approach To Food Safety

Oct 27, 2023 | Health & Safety
Salmonella, a name that often elicits fear in those who have encountered its unwelcome presence, is a well-known term. But what precisely is salmonella, and how does it manifest in various forms? This article is our hope to break down the plethora of salmonella types,...

Sep 20, 2023 | Health & Safety
Listeria, formally known as Listeria monocytogenes, is a bacteria variety commonly found in soil, water, and some animal species. It poses a significant risk to food safety as it has the capacity to contaminate a variety of food items, with a particular penchant for...

May 29, 2023 | Health & Safety, Industrial & General Cleaning
Industrial cleaning is an essential component of maintaining food processing facilities. A clean facility ensures the safety of the food produced and prevents contamination and the spread of bacteria. However, cleaning in these facilities can be hazardous if workers...

Apr 20, 2023 | Health & Safety, Industrial & General Cleaning
Food processing and manufacturing facilities play a critical role in ensuring the safety and quality of the food we eat. However, they are also vulnerable to pest infestations, which can pose a serious threat to food safety and public health. Pests such as rodents,...

Aug 5, 2022 | Health & Safety
Foot-and-mouth disease (FMD) is a highly contagious viral disease affecting cloven-hoofed animals, including pigs, cattle, sheep, goats and deer. It causes mouth sores, fever, lameness and death. The name “foot-and-mouth” refers to the hooves of affected...

Mar 31, 2022 | Health & Safety
Japanese encephalitis, also known as JE, is a viral infection that most commonly affects humans between the ages of 5 and 20. It is most prevalent between May and September when the virus is most active. The disease has a 30 percent fatality rate. There are three...